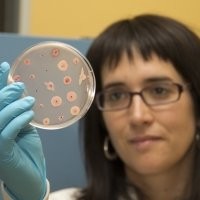
Miren Zumarraga

Company Details
- Employees
- 2
- Address
- Vitoria-Gasteiz, Basque Country
- Website
- http://guserbiot.com
- Keywords
- VITORIA-GASTEIZ.
- HQ
- Vitoria-Gasteiz, Basque Country
- Competitors
- ABOASER, Abogados y Asesores Reunidos, S.L. -Administración de Fincas-, EDICAR PLASTICOS SL, Luznor Desarrollos Electrónicos S.L., INSTALACIONES LUIS URBINA SL, TECNASA, TESOLVIT SL, AGUAS MUNICIPALES DE VITORIA GASTEIZ SOCIEDAD ANONIMA AMVISA VITORIA GASTEIZKO UDAL URAK AB, AIDA VITORIA SL, Invitec - Innovación Vidrio Técnico, Autocaravanas Norte.